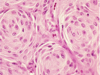
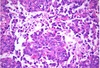
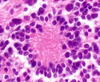
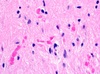

Foster Kennedy Syndrome?
Ipsilateral optic atrophy and contralateral pappilloedema.
Secondary to tumour compression and raised ICP.
Gerstmann Syndrome?
Dominant parietal lobe dysfunction, involving the angular gyrus.
Agraphia without alexia
Finger agnosia
Right to left disorientation
Acalcula
Radiological indication for decompressive hemicraniectomy in MCA stroke?
CT Head infarct involving >50% of MCA territory
+/- PCA or ACA infarct
+/- MRI restricted diffusion > 145cm3
ATRT?
Atypical Teratoid Rhaboid tumours.
WHO grade IV.
10-20% of paediatric CNS tumours under 3 years old.
Poor prognosis with CNS metastasis.
Associated with mutated INI1 tumour suppressor gene on chromosome 22.
Grading of atlantoaxial rotatory subluxation?
Fielding and Hawkins:
I: rotation without anterior displacement of C1
- transverse ligament intact
II: rotation with 3-5mm of C1 anterior displacement
- transverse ligament damaged
III: rotation with >5mm of C1 anterior displacement
IV: posterior displacement of C2
- rare, in rheumatoid
NF1
Incidence 1/3,000 births.
Chromosome 17.
Gene product = neurofibromin.
Occasional pheochromocytoma and common scoliosis.
Malignant peripheral nerve sheath tumour = 2%
Intra medullary cord tumour = astrocytoma
NF2
Incidence 1/40,000
Autosomal dominant.
Chromosome 22.
Gene product Schwannomin/ Merlin.
Cutaneous schwannomas
Cataracts common.
Most common spinal cord tumour = ependymoma
Most common extradural tumour of clivus?
Chordoma
Two most common sites of origin for chordoma?
1) sacrum
2) clivus
CSF tumour marker positive in Germinomas?
Placental alkaline phosphotase
What tumours are associated with raised alpha fetal protein?
Embryonal carcinoma and yolk sac tumours.
Test to distinguish Primary CNS Lymphoma from other HIV mass lesions?
Fluorine-18 flurodeoxyglucose PET. Higher uptake in Primary CNS lymphoma.
Most common posterior fossa primary brain tumour in adults and children?
Adults: haemangioblastoma
Children: polycytic astrocytoma
What is the test dose for intrathecal baclofen?
50micrograms
How is spasticity graded?
Modified Ashworth scale:
0 = normal tone
1 = ‘catch and release’
1+ = catch followed by slight increase in tone
2 = increased tone throughout range of movement but passive movement easy
3 = difficulty with passive movement
4 = Rigid limb fixed in flexion or extension
Mechanism of Baclofen?
GABA-B agonist
Dermatomes of the trigeminal nerve?
Opthalmic V1: Anterior scalp, forehead, upper eyelid, cornea, nose, frontal sinus.
Maxillary V2: Lower eye lid, cheek, upper lip and gums, maxillary and ethmoid sinus
Mandibular V3: Jaw, chin, lower lip, gums and teeth
What are Hartel’s landmarks?
Percutaneous trigeminal rhizotomy.
2.5cm lateral to the mouth
Coronal plane aiming 3cm anterior to the external auditory meatus
Sagittal plane towards the ipsilateral pupil
Anatomical relations of the subthalamic nucleus
STN:
lateral to the red nucleus
medial to the internal capsule
ventral to the thalamus
dorsal to the substantia nigra
The STN is caudal in the diencephalon, close to the junction with the midbrain
What cognard grade has the highest risk of haemorrhage?
Type 2a + b
Describe the cognard grading for dural AV fistulas
Type 1: Antegrade flow in the venous sinus
Type 2a: retrograde flow in the venous sinus
Type 2b: retrograde flow with reflux into cortical vein
Type 3: Direct cortical drainage without venous ectasia
Type 4: Direct cortical drainage with venous ectasia
Type 5: Spinal venous drainage
Medial cranial nerve within the cavernous sinus
Abducens nerve VI
Serviceable hearing in acoustic neuroma
Less than 50dB in pure tone audiogram and greater than 50% in speech discrimination test
Circumventricular organs
Midline areas of increased permeability without the blood brain barrier.
7 in total
Sensory
Area postrema
Lamina terminalis
Subforniceal organ
Secretory:
Posterior pituitary
pineal gland
Subcommissural gland
Median eminence